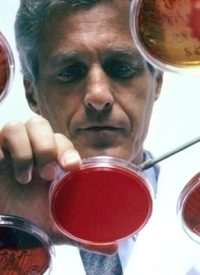
“Superbug” Makes its Way to U.S.

“Superbug” Makes its Way to U.S.
An unwelcomed visitor has made its way into the United States from India: the “superbug.” Antibiotic-resistant bacteria, the New Delhi metallo-beta-lactamase (NDM-1) has the potential to spread worldwide, warn scientists.
Dr. Alexander J. Kallen, a medical epidemiologist and outbreak response coordinator with the U.S. Centers for Disease Control and Prevention’s Division of Healthcare Quality Promotion, explains, “NDM-1 is a newly recognized mechanism of resistance that allows certain bacteria to become resistant to certain antibiotics.”
Food Consumer reports, “NDM-1 is a close genetic cousin of another bacterium that has been present in the US for many years. The challenge in treating these germs is that both produce an enzyme making them resistant to a group of antibiotics called carbapenems, which include penicillin and ampicillin.”
Dr. Kallen indicates, “Unfortunately, carbapenem resistance is not uncommon even in the United States. We have our own homegrown version of NDM-1 that has been recognized for quite a few years. Carbapenem-resistant bacteria (KPC) appear to be transmitted in the US in health-care facilities such as hospitals and nursing homes, and are typically spread from patient to patient from contaminated surfaces and hands.”
However, conditions in India enhance the growth and spread of drug-resistant bacteria. The ready availability of over-the-counter antibiotics in India has helped increase drug resistance. Likewise, since NDM-1 grows in germs found in the intestines, poor sanitation enables the spread of the bacteria.
Currently, three cases of NDM-1 infection have been reported in the United States — in California, Massachusetts, and Illinois.
According to Food Consumer, the infected patient in Massachusetts is an Indian citizen who underwent cancer surgery and chemotherapy in India before traveling to Boston. The other patients recently traveled to India to receive treatment in Indian hospitals as well.
Apparently traveling overseas for medical care is not a new phenomenon. Healthy Living reports, “About 150,000 Americans travelled overseas last year for medical care to save on costs.”
Unfortunately, cutting financial costs in medical care often means reducing the quality of the medical care. Dr. Marc Siegel, an expert in infectious diseases, attributes the emergence of such antibiotic-resistant bacteria as NDM-1 to “lack of cleanliness and sterility in hospitals, too many antibiotics being prescribed and drug companies not developing new antibiotics because they aren’t profitable.”
NDM-1 has spread to Canada, Pakistan, Japan, and nations in Europe as well, with several deaths reported, though the actual number is unknown.
Outbreaks of drug-resistant bacteria have become an increasing problem within the past few years in hospitals and schools, including that of E. coli and methicillin-resistant staphylococcus aureus (MRSA). Fortunately, scientists have been working on a drug developed from the brain tissue of cockroaches and locusts which has proven to kill 90 percent of E. coli and MRSA bacteria.




